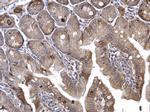
H-Ras Antibody in Immunohistochemistry (Paraffin) (IHC (P))
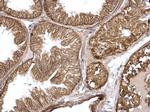
H-Ras Antibody in Immunohistochemistry (Paraffin) (IHC (P))
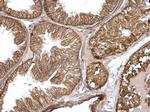
H-Ras Antibody in Immunohistochemistry (Paraffin) (IHC (P))

Search
Invitrogen
H-Ras Polyclonal Antibody
{{$productOrderCtrl.translations['antibody.pdp.commerceCard.promotion.promotions']}}
{{$productOrderCtrl.translations['antibody.pdp.commerceCard.promotion.viewpromo']}}
{{$productOrderCtrl.translations['antibody.pdp.commerceCard.promotion.promocode']}}: {{promo.promoCode}} {{promo.promoTitle}} {{promo.promoDescription}}. {{$productOrderCtrl.translations['antibody.pdp.commerceCard.promotion.learnmore']}}
产品信息
PA5-22392
已发表种属
宿主/亚型
分类
类型
抗原
偶联物
形式
浓度
规格
保存条件
运输条件
RRID
产品详细信息
Recommended positive controls: 293T, A431, HeLa, HepG2, PC-12, Rat2, HRAS-transfected 293T, RFL6, PLC5Rat2, RFL6, PLC5.
Predicted reactivity: Mouse (100%), Rat (100%), Xenopus laevis (100%), Chicken (100%), Rhesus Monkey (100%).
Store product as a concentrated solution. Centrifuge briefly prior to opening the vial.
靶标信息
Monomeric G protein Ras functions as a molecular switch linking receptor and nonreceptor tyrosine kinase activation to a number of downstream signaling pathways leading to distinct cytoplasmic or nuclear events. Each mammalian cell contains three Ras proto-oncogene coding for closely related Ras proteins: H-, K-, N-Ras. Oncogenic mutations in Ras genes are present in ~30% of all human cancers. Constitutive activation of Ras due to mutations or overexpression stimulates proliferation and inhibition of apoptosis. K-Ras mutations are common in pancreatic, colorectal and nonsmall-cell lung carcinomas; H-Ras mutations are common in bladder, kidney and thyroid carcinomas; N-Ras mutations are found in melanoma, hematological malignancies and hepatocellular carcinaoma.
仅用于科研。不用于诊断过程。未经明确授权不得转售。